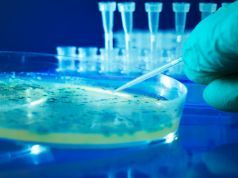
Chipotle E. Coli Outbreak in America’s Heartland Remains a Mystery

Obama Takes Action on Guns — Gun Sales Skyrocket!
In his last year in the White House, President Obama started 2016 off with what may appear to be a bang, but is really...
New Year Brings International Stock Plunge
The New Year brings many new things, and this year, January 4 brought uncertainty to investors. Large drops in both American and international stock...
20 Ways to Feel Young Again
If only there was a fountain of youth that you could drink from, especially when life has you feeling even older than you really...
6 Toxic Things to Get Out of Your Kitchen
Eating good quality food is one of the most important things we can do for our health, but it can really add up in...
Slash Your Colon Cancer Risk and 8 Other Reasons to Eat Dried Plums
Research presented at the 2015 Experimental Biology Conference in Boston, Massachusetts, has brought forward exceptional news in the fight against colon cancer. This research...
How to Make Your Organic Foods Last Longer
If you are transitioning from conventional produce to organic, you may be shocked at how much faster organic food starts to go bad. Your...
Anti-Trump Skywriting at the Rose Parade Stole the Show
Anti-Trump messages stole the show and filled the sky during the 127th Rose Parade in Pasadena, California last Friday. "America is great! Trump is...
Ancient Horseshoe Crab Endangered Over Blue Blood Profits
The horseshoe crab, Limulus polyphemus, is very, very old. It is not the most aesthetically pleasing animal in the ocean, and if you saw...
Chipotle E. Coli Outbreak in America’s Heartland Remains a Mystery
The cause of the Chipotle E. coli outbreak in America’s heartland remains a mystery. From coast to coast, state and federal health officials are...
Are You Wearing Clothes Treated with Toxic Formaldehyde?
Picture this: You’re out shopping and happily pick out some fresh new threads. You come home and put on a mini fashion show in...